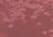

BACHELOR OF ARCHITECTURAL DESIGN
DESIGN STUDIO
BALLOTING POSTERS &
LEADER BIOS







Studio Leader: Prof. Dr. Alisa Andrasek


![]()
BACHELOR OF ARCHITECTURAL DESIGN
DESIGN STUDIO
BALLOTING POSTERS &







Studio Leader: Prof. Dr. Alisa Andrasek


“Confronted by planetary limits yet armed with unprecedented tools, architecture needs to synthesise ecology, computation, matter, and creativity into a renewed high-resolution practice—one that crafts environments attuned to humans and the planetary health.” Alisa Andrasek
Set on Victoria’s Shipwreck Coast, a dramatic terrain of cliffs, sea stacks and erosion fields under increasing tourist pressure, this studio explores architecture as a multi-scalar system. Students will engage in speculative design across two orders of scale.

At the macro level, natural systems such as erosion, fluid dynamics or sedimentation will be cross-bred with architectural and structural tectonics from selected precedents, such as Konrad Wachsmann’s lattice systems, to generate organisational morphologies adaptive to the site.
At the micro level, these patterns will be hybridised with dry-joint timber construction to generate architectural “chunks” — towers, pavilions, shelters — embedded within the macro field and resolved through tectonic clarity and material articulation.


High-resolution organisational and tectonic expressions will be deployed to mediate public access, terrain adaptation, and ecological support. Projects may accommodate micro-habitats, environmental sensing, or slow-tourism infrastructure, with an approximate program ratio of 10% human use and 90% support for ecological, atmospheric, or machinic systems.
Students will engage multimodal AI tools such as diffusion models, AI video synthesis and large language models, along with Rhino modelling and narrative generation. The emphasis is on cultivating bespoke design languages and exploring new models of authorship and systemic intelligence.

Times & Location:
Mon 9:30–12:30 | 100.05.006
Thu 9:30–12:30 | 100.04.006





Students work in teams of 3. Basic Rhino modelling skills are required. Generative AI skills are not required but strongly encouraged. Student will need Midjourney subscriptions.





















This studio explores the limits of architectural control — over heritage, over history, and over the cultural bodies it seeks to frame — proposing instead a

Flores i Prats, Gordon Matta Clark, David Chipperfield, Bernard Tschumi, OMA, Rachel Whiteread, Sigurd Lewerentz, Carlo Scarpa Sverre Fehn, Assemble
Sacha Hickinbotham
S2 2025 Monday 1800-2100 Thursday 1800-2100






































This is a studio about


v 3.0
Bottom-up Design Process


Indexical and Non-indexical Design Process
Computational Design
VFX Animation
Physics Engine
Advanced 3D Modelling
AI Diffusion Models

Desktop 3D Printing


| PREREQUISITES | MATERIALS AND PHYSICAL MODELS | KEYWORDS


Basic knowledge in Rhino and Grasshopper is required. No prior experience in Houdini, ZBrush, Diffusion tools or coding is required.
Students will produce physical models weekly using 3D printers. Please note that there will be material and fabrication costs associated with 3D printing.

While 3D print facilities are available at the RMIT DSC Workshop, RMIT Library Makerspace and City of Melbourne Makerspaces, lead times can be significant. In such cases, outsourcing is an option, though this will incur additional costs.

| RMIT ARCHITECTURE AND URBAN DESIGN
| 2025 S2 – BACHELOR DESIGN STUDIO
| STUDIO LEADER

| TIME & LOCATION
MONDAYS & THURSDAYS
18:00 - 21:00, 100.06.007 ALAN KIM





| STUDIO DESCRIPTION

This studio investigates the intricate relationships between geological formation processes and architectural design, with a particular emphasis on ephemeral forces and their amalgamations. The core objective is to explore how digital generative methods and AI-driven processes can be used to simulate, abstract, and translate geological formation into architectural form. Drawing from processes such as sedimentation, erosion, accretion, and stratification, the studio examines how architecture can emerge from the dynamic layered interactions.
Students will analyse and synthesise geological processes— both visible and invisible—as frameworks for generating spatial conditions. These investigations employ both indexical and non-indexical approaches to material expression. The design agenda is to create site-specific narritives that respond to geological temporality and transformation, resulting in architectural systems that move beyond blobism and toward structured, morphodynamically informed formations.
Throughout the semester, students will develop procedural workflows using a combination of the VFX software Houdini and AI diffusion image generation tools. These platforms will be used to establish dynamic feedback loops between simulation and image synthesis, enabling the exploration of geological layering, tectonic shifts, and erosive transformations. Houdini’s physics-based simulations allow for precise modelling of complex geological processes, while AI diffusion tools provide speculative and associative imagery that expands the design vocabulary. Together, these tools facilitate the transition from ephemeral digital formations to materially grounded and tectonically expressive architectural proposals.
The semester is structured into three phases. The first phase (Weeks 1–3) focuses on the generation of ephemeral digital abstractions, where students investigate geological behaviours through digital and physical artefact production. The second phase (Weeks 4–6) shifts toward architectural translation, as students transform digital patterns into defined architectural elements and fabricate physical models. The third phase (Weeks 7–14) centres on site-specific design work, where students collaboratively develop architectural interventions that integrate the ephemeral and geological logics established earlier.
This studio challenges students to move beyond traditional design approaches and engage deeply with the language of geological formation as a driver for architectural innovation. Through iterative digital and physical experiments, students will develop siteresponsive proposals that are materially rich, formally complex, and conceptually grounded.
| TECTONIC FORMATION LAB
This studio is part of a group of studios and electives run this semester that are aligned with the RMIT Architecture | Tectonic Formation Lab, which will collaborate through combined reviews and symposia.
| GROUP FRAMEWORK







BAS 2025 Sem 2 Lecturer Dr Peter Brew
EXTRA housing
Monday Afternoon 2.30
We need to develop a new housing type that allows us to imagine new ways of being in the world. Architect BREW KOCH.
We assume that the property industry is broken . Reading the news it would seem that nobody is happy, First Home buyers, tenant’s, Architects Builders Unions, urban planners, the productivity commission. We want to introduce a new model of property. To create new models of housing and to reimagine the building industry..
If we consider this description by James Graaskamp “Unlike many mass-production industries, each real estate project is unique and the development process is so much a creature of the political process that society has a new opportunity with each major project to negotiate, debate, and reconsider the basic issues of an enterprise economy, i.e., standing to participate in the decision process. Thus the development process remains a high-silhouette topic for an articulate and politically sophisticated society.”
Currently Property, Labour relations job skills taxes levies and fees combine perfectly to pro-
duce lots of suburban villaswe know that this pattern is an disaster on so many levels but the system that produces them is highly
Suburbia like Robo debt is not an accident ,it is design feature of the current settings, it is the expressed of the systems intentionality. We can see tht it is possible to replace the suburban with another product, though to do that one has to properly recognise the reasons why things don’t change. This was a problem that Thomas Kuhn identi-
It is possible to see the problem of the industry is
can discuss we have come to a narrow path of options for each project, According to the Productivity commission the industry is now producing Less housing that is more unaffordable. This has the effect of raising the value of existing housing, and by default land prices which further feeds the price spiral. It is possible to reimagine the relationships to bring about a very different outcome.
In post war France the Citroen is an example of an product that changed how cars were perceived, how they were produced and subsequently what they were used for, in our time the I phone did something similar.





LAURA ZAMMIT
SAM
MONDAY 3-6PM
THURSDAY 6-9PM

In a world where decades are occurring in years, and our lives are increasingly mediated by the digital, we turn to the material. For us to understand time, we need to be able to see its have to get up close.
capital allows, this often ensures a developer’s special. Our job is not to make everything, but it is to make room for studio.
This studio is a proposal for an architecture that assists a nascent economy, re-texturising a for non-human advocacy, a constellation of emergent approaches and old bricks, it’s about smuggling catharsis into parliament and proving that architecture too, might be sentimental.
This is a department of extraction and a repository for the non-human. This is a material practice where the object is a symptom.
The apparent enlargement of an object by an optical instrument. Called also power.
Magnifying detail, and using it as a mirror to hold up to architecture.
Time
We will design within short and long scales of time. Reading time through touch. Playing with method and
Texture
production, foregrounding the sensory and the situated. Layering knowledge, and a history of architectures.
Situated Project(s) will be anchored at 87 Spring St, a holding bay for the cultural infrastructure you design.
Making
We will re-code interior logic and tacit knowledge into a cultural axonometric and angelic section. Dayjob is about doing the work, regularly. Students will undergo weekly translations of (irl) physical objects into architectural proposals, using the studio’s key themes as a starting point for process-based evolutions. Where relevant, workshop utilisation will be encouraged.


























































































In a world where we unconsciously acknowledge the resources that are required to remove waste from our environments, water treatment becomes one of the largest pieces of infrastructure that is shrouded from our every day.
Historically water has been celebrated through civic and infrastructure interventions including step wells, fountains, and aqueducts. The treatment of wastewater becomes a fundamental way of considering how we can reduce energy consumption and providing infrastructure for our growing cities.
90% of Melbourne’s wastewater is serviced by two sewage plants located in western and eastern Greater Melbourne. These hold and process 350 billion litres of sewage per year which equates to:
200 x MCGs
264 x Melbourne CBD Hoddle Grids
3,240 x Bunnings Stores
140,000 x Olympic Swimming Pools
The design studio questions the benefits of localising water treatment plants by decentralising and integrating smaller more economic plants into our communities. The project focuses on making the infrastructure visible to bring a greater awareness and understanding of what is required for the servicing of our cities and communities. The water treatment plants would carry a civic presence providing use beyond being utilitarian. Spaces of gathering. Spaces of engagement. Spaces that service the local.
Building on the ongoing work undertaken by MUIR and Finding Infinity, the studio will ask the students to engage with a variety of scales of site formally testing and challenging the concept. The studio will involve a tour of Melbourne’s western treatment plant. Finding Infinity and other industry partners will be involved through the briefing and review process.
The studio will be undertaking investigations into the memory of place and how this informs a language of place. Students will be exploring a number of design methodologies, design tools, in order to understand the formal nuances of place, context. The role of the architectural precedent will be explored rigorously understanding the various languages that come with building typologies. These methodologies will be implemented for students to design a place of civicness that challenges preconceived notions of what might be initially understood formally.
Students will be engaged with rigorous site, program and precedent analysis through research, collage and drawing, drawing, drawing. Students will be working throughout the semester on individual projects but are encouraged to support and learn via their peers.
BA ARCHITECTURE DESIGN STUDIO S2 2025
MONDAY 2.30-5.30PM, THURSDAY 9AM-12PM
AMY MUIR
LEARNING FROM DESAKOTA
STUDIO LEADER: YIQIAO ZHAO
MONDAY 12PM-3PM
THURSDAY 3PM-6PM

Desakota, a term combining the Bahasa words for “village” and “city”, originally describes a spatial condition where rural and urban features blur. In this studio, Desakota is interpreted as a logic – the coexistence of diverse programs,informal and formal systems, traditions and emergent demands, in tight proximity.
one observation emerges: loosely regulated areas allow for a more rapid spatialisation of human needs. These areas, while typically seen as unplanned, offer direct insight into spatial necessity, adaptation and clarity of intent.
This studio asks not how to “urbanise” the Desakota, but how to Desakota-ize the urban.
in other words, how might formal cities incorporate the informal, the ad hoc, the improvised and the irregular. The studio explores concept and mechanism of Desakota through the design of “patches”- informal, often parasitic additions embedded within existing context.
You will explore three areas: The Hoddle Grid, Footscray, and north Richmond. Walk. Draw. Film. Map.
Morwell’s past cannot be separated from the detrimental consequences of the fossil fuel industry. Its history runs lockstep with the history of colonisation and industrialisation. The once thriving company town
environmental and social disrepair. Each new decommissioning of the region’s power plants leads to further job losses, disenfranchisement and the loss of hope.
The project will be for a proposal for a new model for LIVING and WORKING that challenges outdated notions of domesticity that can’t see beyond the white heteronormative nuclear family and the explicit separation of public/private. This project will draw on the rich history of communal and cooperative living and engage with ideas of ownership, property, and land.
The ambition of the project should be a straight-forward and unsophisticated architecture, yet one that is politically and socially radical. The project should elevate the everyday, be robust and occasionally superb. It should place a priority on ideas-based outcomes with rigorous plans, cleverly composed space and the assemblage of everyday materials; we are striving for an architecture that is uncanny.
Trip Planned for Week 02 or Week 03

Mondays and Thursdays 2.30pm to 5.30pm

This studio is based on the premise that a carefully articulated and authentic research question arises from observing the processes of design. How you position your work critically arises through the action of design, rather than preceding it.
The work of the studio will be divided into two equal parts: work done in class and work done between classes.
In-class work will take the form of guided coloured hand drawings on a single A1 sheet that students will develop over the entire semester. This work will evolve into a layered palimpsest of automatic and uncritical production.
Work done between classes will
work through descriptive writing, theoretical/poetic/referential writing, drafting, 3D modelling, and physical model making. This work will be a critical, analytical, and editorialised
Brief
A site, building type, and brief for a major public building will be provided.
The building you design in response will be required to meet planning conditions, and the constraints of the national construction code.
the automated and layered in-class work.
You will learn to trust your ability to produce material before you understand what it means or aims to achieve. You will learn to discover ideas within your work after the fact, on a twice-weekly basis. You will come to understand that your inability to
attempt is an inevitable and productive part of the design process. You will develop the skill of critical analysis
as it develops. And you will create a piece of work that exceeds your understanding of your capabilities.
In class, you will be asked to produce intuitively. Between classes, you will be asked to analyse what motivates your intuitive actions.

Jan van Schaik
Your tutor is an architect, artist, and strategist based in Melbourne.
He runs MvS Architects, teaches and researches at RMIT Architecture & Urban Design, and is design director at the creative-sector consultancy Future Tense.
Jan is the founder of the performance series +Concepts and the creator of

And, in turn, you will learn how to train your intuition.
Notes
There will be one local site visit at the start of semester, and this studio will not involve any group work.

two series of artworks: Lost Tablets and The Red Box.
He is a practiced designer and supervisor, with over a decade of experience empowering bachelor’s, master’s, and PhD candidates by teaching the methods of critical thinking through the process of design.
More information at janvanschaik.com

Dr Michael Spooner is a Senior Lecturer in the School of Architecture & Design . He maintains a critical practice composed of teaching, writing, and speculative architectural projects.
Design Studio: Salt, Saliva, Sperm, Sweat (MAS) e: michael.spooner@rmit.edu.
au

Dr Patrick Macasaet is Lecturer at RMIT Architecture, Research Leader at RMIT A&UD Immersive Futures Lab, and Principal of Superscale Architecture.
Design Studio: Continuums, Data, Being 2: RMIT City North (MAS) e: patrick.macasaet@rmit. edu.au

Anna Jankovic is an architect, director of Simulaa. An Associate Lecturer at RMIT Architecture, Anna teaches Design Studio, History and Professional Practice, and supervises Major Projects, alongside her research on adaptive and resilient architecture that explores cultural, historical, and timebased design.
e: anna.jankovic@rmit.edu.au

Brent Allpress is a New Zealand senior academic at RMIT Architecture, Melbourne, teaching design, history and theory with a focus on alterations, ornamentality, digital design practices, AI 3D modelling, urban infomatics and open source Intelligence. He was Creative Director and exhibitor in the Venice International Architecture Biennale event “Knowledge Transfer” (2023)
Design Studio: Alter: To Make Other

Audrey Avianto is an RMIT Architecture Alumna and Graduate at City Design, City of Melbourne. Her design ethos has been shaped by her experience studying under Jan Gehl. She has a diverse set of experiences working across urban design, architecture, design advocacy and urban research, in Melbourne and Denmark.
Design Studio: You had to be there 2

Will Bennie is a Graduate of Architecture and RMIT Architecture Alumnus. Will’s professional work spans architectural design, sustainability, and academic work as a sessional tutor at RMIT. Will is currently working as a senior designer at Heliotope Studio.

Professor Alisa Andrasek is a Professor of Architecture at RMIT School of Architecture & Urban Design.
Design Studio: AI Acclerated Architects: Patterns2Tectonics

Brooke Barker is an Urban Designer at City of Melbourne who has worked across Victoria on urban strategy, architecture and design projects. Brooke has been involved in installations for Melbourne Knowledge Week and Open Jazdow (Poland) that embed her interest in accessible design communication and meaningful engagement practices.
Design Studio: You had to be there 2

Charlie Boman is an RMIT Architecture alumnus and current PhD candidate at RMIT with the RMIT Tectonic Formations Lab. Charles’s research and teaching are closely linked, often exploring the intersection between design tools, fabrication methods, and material behaviour.

Design Studio: Localhost Grit
Peter Brew is a Lecturer at RMIT Architecture in the School of Architecture & Urban Design, RMIT University, and a Director of Architect Brew Koch.

Design Studio: Xtra
Design Studio: This Tortured Earth
Chris Buchhorn is a Registered Architect, Senior Associate at ARM Architecture and an RMIT Architecture alumnus and recipient of the Anne Butler Memorial Medal for S1, 2021. His approach to architecture is one of optimism and opportunity. Intrigued by the ‘what-if’ that motivates architectural discovery through rigorous testing and experimentation.
Design Studio: Iterum

Allan Burrows is a practising architect and sessional academic based in Melbourne (Naarm/Birrarung-ga). His research focuses on how architecture mediates contemporary living conditions within interdisciplinary systems and institutions.


Design Studio: Lifework
Charles Deicke is a graduate from the Melbourne School of Design and is the Director of the emerging architecture practice, Paula. He has taught as a Design Studio Leader in the RMIT Bachelor of Architecture program since 2023, successively running the design studios titled Bland God and Sorcerer alongside Darcie Vella.
Design Studio: Alchemy

Mitch Gow is a Senior Architect at City Design, City of Melbourne. With a commitment to placebased design, he strives to deliver projects that respond to their local context and bring joy to occupants, the public realm and connected ecosystems. Mitch has led award-winning projects of various scales and typologies and particularly enjoys working with existing structures in adaptive retrofit projects.
Design Studio: You had to be there 2

Sacha Hickinbotham is an RMIT Architecture alumnus, a UK Registered Architect and a masters graduate from The Bartlett School of Architecture. The culmination of his architectural experience at practices such as Studio Bright, OMA, and Carmody Groarke, has led him to conduct his own architecture and design projects both at home and abroad.
Design Studio: Limits of Control

Jennifer Chen is a graduate of the RMIT Master of Architecture Program, recipient of the RMIT Leon van Schaik Medal, and a Project Professional at NH Architecture. Since 2022, she has taught into several various courses at RMIT, such as Portfolio, 20th Century History, and design in First Year Foundation.
Design Studio: Vade Mecum
Nicholas Dimitrelos is an RMIT Architecture alumnus and sessional Design Studio Leader. His work explores architecture as a responsive process, deeply rooted in memory, materiality, and social engagement. to create empathetic and meaningful design experiences. He is past recipient of the Antonia Bruns Memorial Medal.
Design Studio: Bandicoot

William Grosby is an Architect at Rob Kennon Architects (RKA). He is an RMIT Architecture alumnus and has at the Bachelor and Masters level at RMIT and Melbourne University School of Design. William is interested in the architectural artefact and its capacity to define a social, economic, or cultural sensibility.
Design Studio: Above the Clouds

Isabelle Jooste is an ARBV registered architect and sole practitioner. Her research focuses on investigating what it means to pursue craftsmanship within contemporary design practice, particularly through digital sculpting and material exploration using robotics.
Design Studio: This Tortured Earth

Alan ‘Ho Kyeong’ Kim is a Ph.D. Candidate and studio leader specialising in large-scale 3d printing and innovative material integration with emphasis on carbon fibre, fiberglass, polymer and poly-epoxides to produce intricate fibrous tectonics.


Design Studio: Ephemeral Geologies: Material Diffusions
Luke Martelli is is an RMIT Architecture alumnus and a sessional academic in the Bachelor of Architectural Design program across both Design Studios and History courses. His work is interested in observation and reactivity, the value of phenomenological curiosity, and finding relationships and methodologies which work to embed complexity within spaces of conformity.
Design Studio: Bandicoot

Amy Muir is director at MUIR Architecture and brings over 15 years of experience in high-end residential, commercial and public architecture. Amy holds degrees in both Interior Design, and Architecture from RMIT. Amy was the AIA Victorian Chapter President and recipient of the AIA National Emerging Architect Prize in 2016.
Design Studio: Present

Georgia Rumble is an RMIT Architecture alumni and Graduate of Architecture at Architectus. Her practice aspires to use the lens of the architectural profession, gaming environments and AI to unlock new ways of exploring architecture. Georgia was recipient of the Antonia Bruns Medal for her Major project and was recently exhibited at the Athens Digital art festival.
Design Studio: Localhost Grit

Peter Knight has taught at RMIT since 2010, across design studios, major project, tech and electives. He works in practice with experience in residential through to commercial, institutional, civic and infrastructure. Digital technology specialist and associate at Denton Corker Marshall. Landcare & Conservation enthusiast.
Design Studio: Vogue Daddy
Dr Hesam Mohamed is a registered architect, researcher, and part-time lecturer, with an extensive architectural experience gained as a director of design practice DEFORM. His research practice focuses on the application of advanced manufacturing within architectural contexts, and has involved leading projects at RMIT’s Tectonic Formation Lab in the recent years.
Design Studio: Interstice

Jack Murray is a registered architect, spatial designer, and sessional staff member at RMIT University. His work explores interdisciplinary methodologies, performance and play. He is interested in the relationships between cultural working methods and architecture, and interactions between people, culture, and civic space.
Design Studio: Private Fears in Public Places

Jan van Schaik is registered architect, artist, and strategist based in Melbourne. He leads MvS Architects, teaches and researches at RMIT Architecture & Urban Design, and directs the design components of creative sector consultancy Future Tense.
Design Studio: A Reflective Practice

Dale Schlosser is a design architect and Associate at NH Architecture. He has worked on large-scale complex projects predominantly in and around Melbourne. He has taught several studios in the Bachelor’s program since 2018.

Holly Shannon is a recent graduate from the RMIT Master of Architecture program, where her major project received the Peter Corrigan Medal. She is currently working as a Graduate of Architecture at Denton Corker Marshall.
Design Studio: Type B

Riley Sherman is a practicing architect with experience in residential, educational, and civic projects across Australia, India, and the US. Through teaching and practice, he explores how architecture can shift from fixed forms to circular, responsive systems attuned to context.

Design Studio: Vogue Daddy
Nikola Sormaz is a Graduate of Architecture at NH Architecture, and sessional tutor at RMIT. Having previously taught Architecture History Introduction and C20 History, he is interested in the role of critical thought and its potential to challenge traditional notions of value, representation, and critique in Architectural design.

Design Studio: Devil in the Detail
Peter Stasios is an RMIT Architecture alumnus and an architect that works within practice and education. Peter has over six years teaching experience at MSD, having run masters studios since 2017. Peter has gained experience working across a variety of typologies at different scales with the consistent through-line being the use of architecture as a vehicle to investigate and understand our world.
Design Studio: Above the Clouds

Darcie Vella is an RMIT Architecture alumna and works at Kerstin Thompson Architects. She has taught as a Design Studio Leader in the Bachelor of Architecture program since 2023, successively running the design studios titled Bland God and Sorcerer alongside Charles Deicke.
Design Studio: Alchemy

Design Studio: Vade Mecum
Samuel Torre is `a graduate of architecture from Melbourne, his education spanning across RMIT, Milan Polytechnic and KTH (Stockholm). He is interested in how the relationships we have between each other (people, disciplines, non-humans) inform the cultural and physical infrastructure of our world(s).
Design Studio: Dayjob
Laura Zammit is an RMIT Architecture alumna and practicing at Genton. She has worked across large scale civic and industrial projects and has previously taught into the firstyear foundation program in the design studio Babylon.
Design Studio: Dayjob

Yiqiao Zhao is is a Graduate of Architecture with experience practicing in Indonesia, Australia, and China. Her work engages with research based and speculative design methodologies, with an interest in human experience and social dynamics. She led a Master design studio at RMIT last semester with a focus on urban patchwork and mixed-use.
Design Studio: Informal Patches: Learning from Desakota